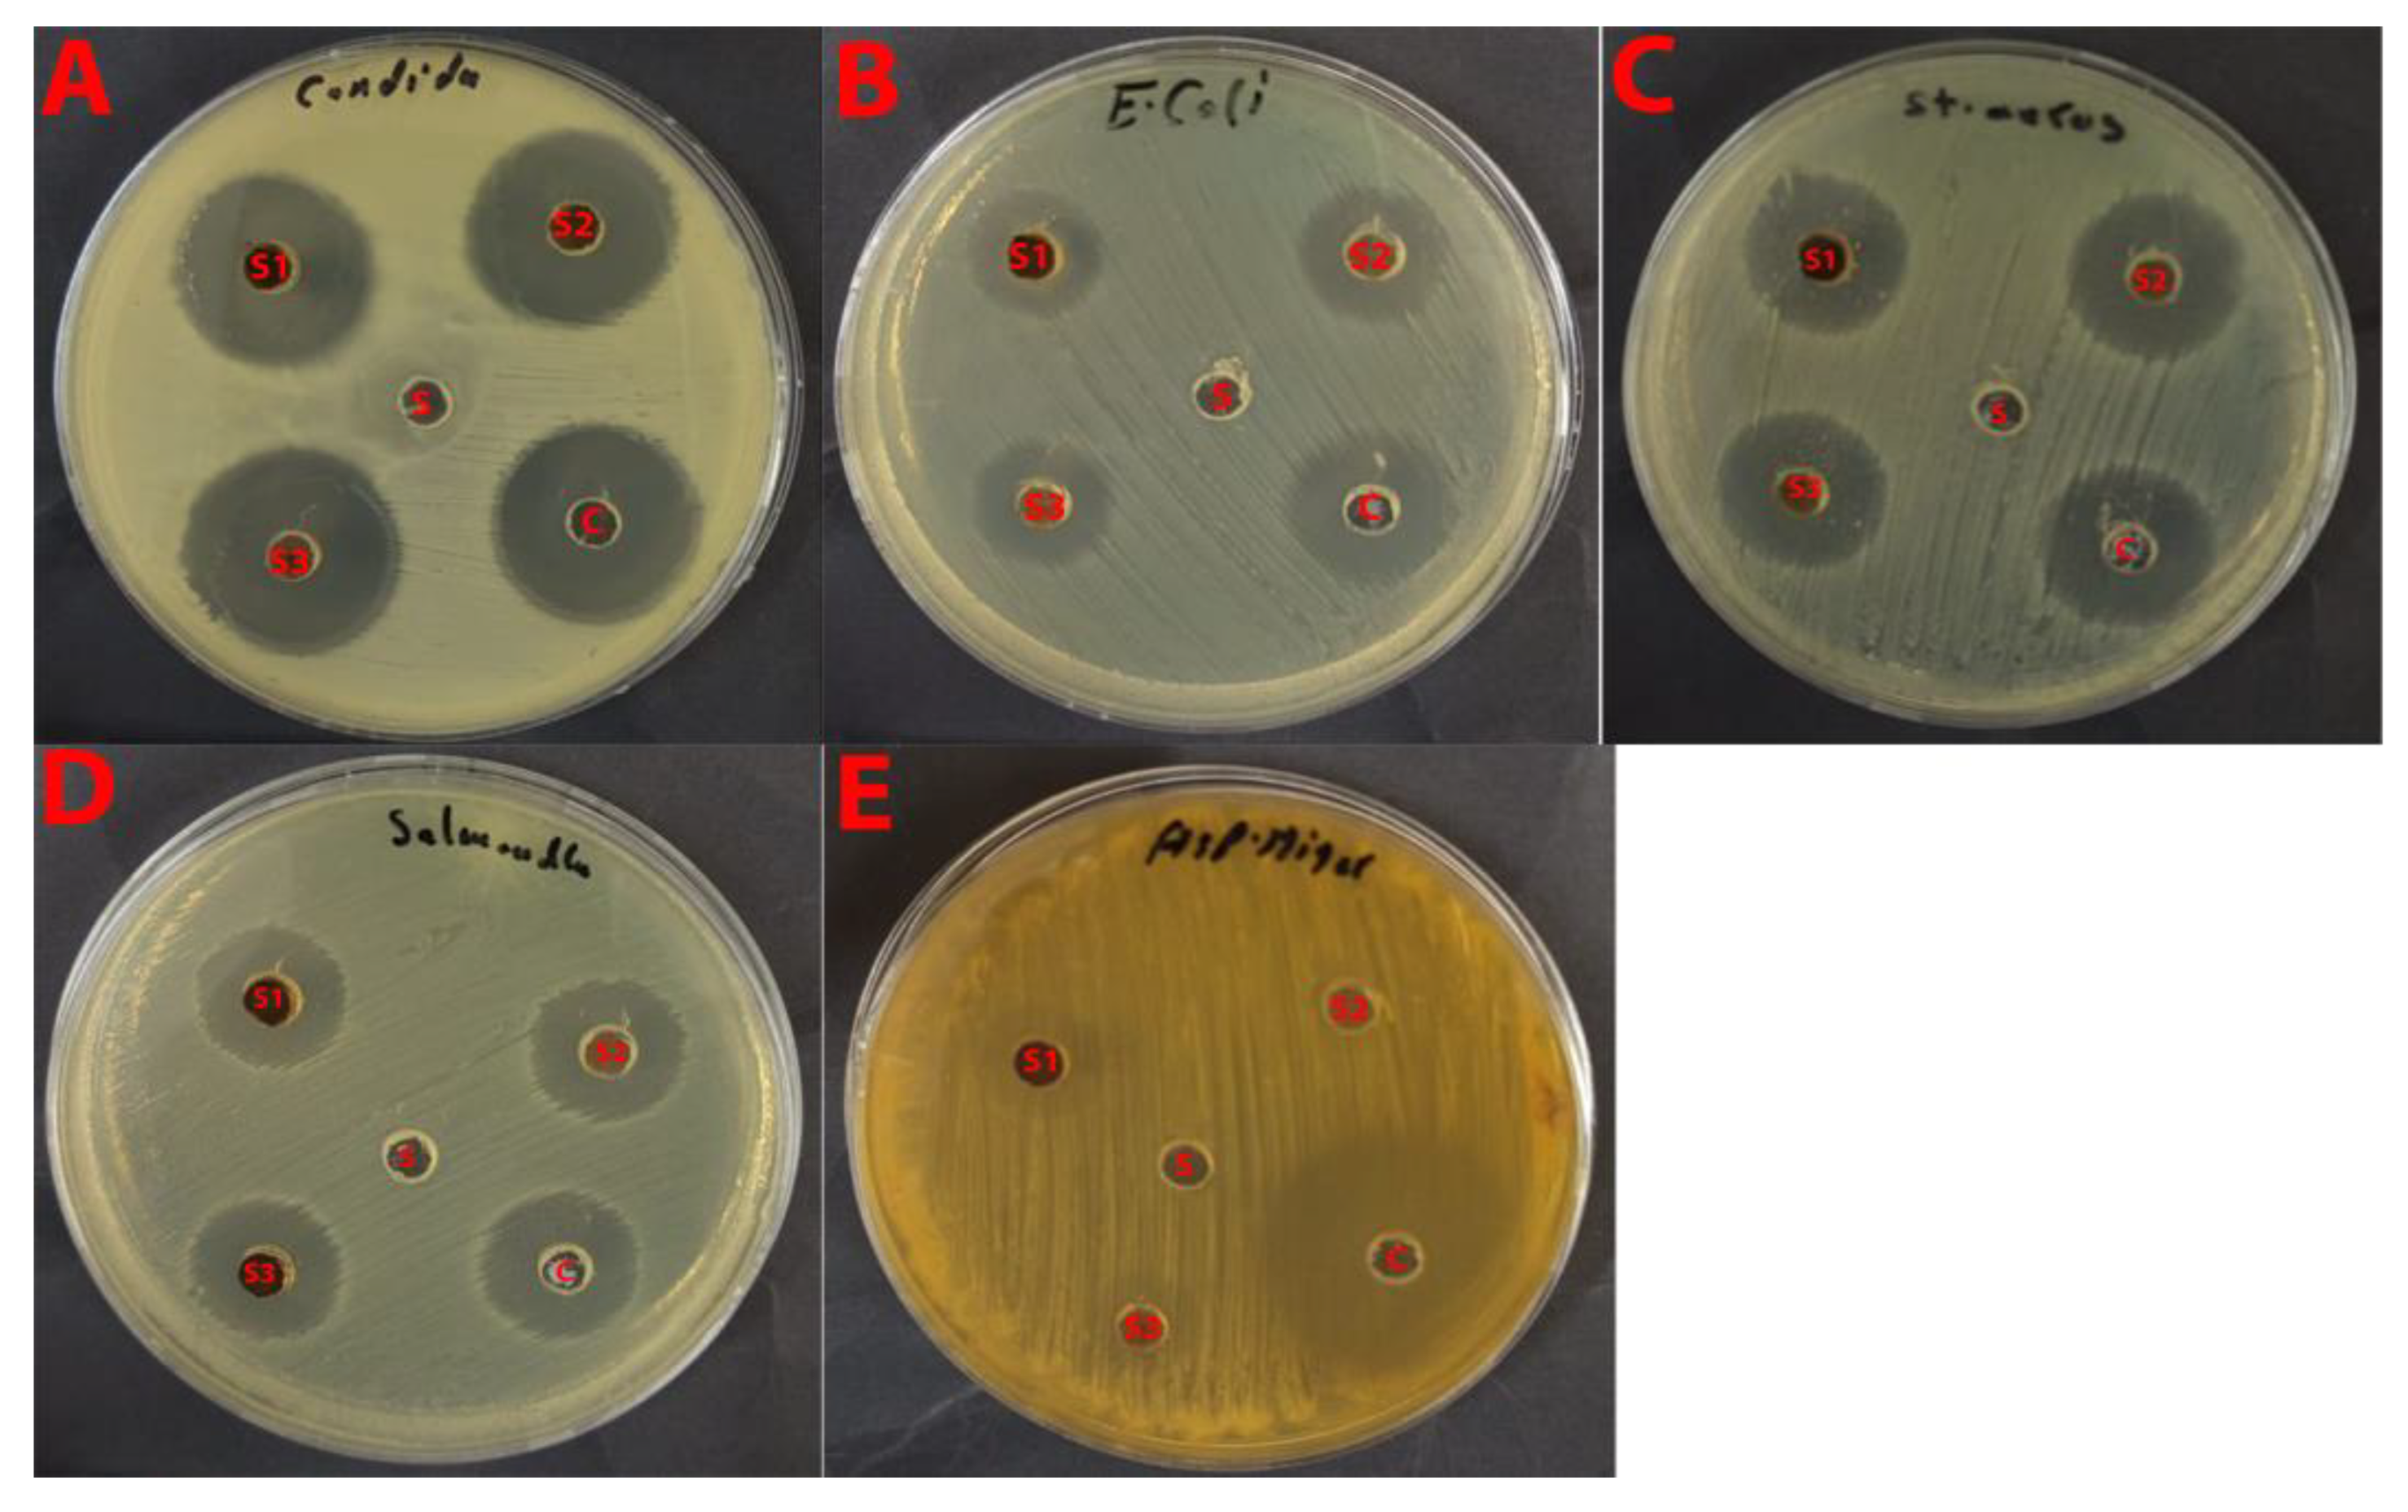
Catalysts 15 01001 g011 Catalysts 15 01001 g011

Synthesis of Plant-Mediated Silver-Doped Metal Oxides Using Catharanthus roseus and Evaluation of Their Catalytic and Biological Activities
Abstract
1. Introduction
2. Results and Discussion
2.1. FTIR Characterization of La/Ag and La/Y/Ag Nanocomposites
2.2. SEM–EDX Characterization of La/Ag and La/Y/Ag Nanocomposites
2.3. XRD Characterization of La/Ag and La/Y/Ag Nanocomposites
2.4. Application of Prepared Materials
2.4.1. Catalytic Reduction Study
Effect of Different Amounts of La/Ag in the Reduction of MB and La/Yt/Ag with MO
Effect of Different Concentrations of Dyes
Effect of NaBH4 Concentrations
Recyclability of La/Ag and La/Y/Ag
Catalytic Efficiency of La/Ag and La/Y/Ag in Real Water Samples
2.4.2. Photocatalytic Degradation Study
Effect of Different Amounts of Catalyst on Photocatalytic Degradation of AO
Effect of Different Concentrations of AO with La/Ag
Recyclability of La/Ag with AO
Photocatalytic Efficiency of La/Ag in Real Water Samples
2.4.3. Antimicrobial Activity Study
Antifungal Activity
Antibacterial Activity
Comparative Analysis
3. Experimental
3.1. Materials
3.2. Preparation Methods
3.2.1. Preparation of the Plant Extract
3.2.2. Preparation of La/Ag
3.2.3. Preparation of Y/Ag
3.2.4. Preparation La/Y/Ag
3.2.5. Characterization
3.2.6. Catalytic Reduction Study
3.2.7. Photocatalytic Degradation Study
3.2.8. Antimicrobial Activity
Microbial Strains and Culture Conditions
Sample Preparation
Incubation and Measurement
Quality Control
4. Conclusions
Author Contributions
Funding
Data Availability Statement
Acknowledgments
Conflicts of Interest
References
- Bayda, S.; Adeel, M.; Tuccinardi, T.; Cordani, M.; Rizzolio, F. The history of nanoscience and nanotechnology: From chemical–physical applications to nanomedicine. Molecules 2019, 25, 112. [Google Scholar] [CrossRef]
- Nandre, V.; Jadhav, Y.; Das, D.K.; Ahire, R.; Ghosh, S.; Jadkar, S.; Kodam, K.; Waghmode, S. Nanomaterials for sensors: Synthesis and applications. In Advanced Nanomaterials for Point of Care Diagnosis and Therapy; Elsevier: Amsterdam, The Netherlands, 2022; pp. 477–492. [Google Scholar] [CrossRef]
- Ghorbanpour, M.; Fahimirad, S. Plant nanobionics a novel approach to overcome the environmental challenges. In Medicinal Plants and Environmental Challenges; Springer International Publishing: Cham, Switzerland, 2017; pp. 247–257. [Google Scholar] [CrossRef]
- Ahmed, S.; Ahmad, M.; Swami, B.L.; Ikram, S. A review on plants extract mediated synthesis of silver nanoparticles for antimicrobial applications: A green expertise. J. Adv. Res. 2016, 7, 17–28. [Google Scholar] [CrossRef]
- Beyene, H.D.; Werkneh, A.A.; Bezabh, H.K.; Ambaye, T.G. Synthesis paradigm and applications of silver nanoparticles (AgNPs), a review. Sustain. Mater. Technol. 2017, 13, 18–23. [Google Scholar] [CrossRef]
- Mekuye, B.; Abera, B. Nanomaterials: An overview of synthesis, classification, characterization, and applications. Nano Sel. 2023, 4, 486–501. [Google Scholar] [CrossRef]
- Iravani, S. Green synthesis of metal nanoparticles using plants. Green. Chem. 2011, 13, 2638. [Google Scholar] [CrossRef]
- Patel, V.; Berthold, D.; Puranik, P.; Gantar, M. Screening of cyanobacteria and microalgae for their ability to synthesize silver nanoparticles with antibacterial activity. Biotechnol. Rep. 2015, 5, 112–119. [Google Scholar] [CrossRef] [PubMed]
- Munir, H.; Bilal, M.; Mulla, S.I.; Khan, H.A.; Iqbal, H.M.N. Plant-mediated green synthesis of nanoparticles. In Advances in Green Synthesis: Avenues and Sustainability; Springer International Publishing: Cham, Switzerland, 2021; pp. 75–89. [Google Scholar] [CrossRef]
- Nayak, S.; Ghugare, P.; Vaidhun, B. Green-synthesis of silver nanoparticles by Hygrophila auriculata extract: Innovative technique and comprehensive evaluation. Indian J. Pharm. Educ. Res. 2021, 55, s510–s517. [Google Scholar] [CrossRef]
- Anandam, S.; Indira, K. Antibacterial activity of biosynthesized ferric oxide nanoparticles using Cissus Quadrangularis extract. Res. Sq. 2021. [Google Scholar] [CrossRef]
- Alshammari, S.O.; Mahmoud, S.Y.; Farrag, E.S. Synthesis of green copper nanoparticles using medicinal plant Krameria sp. root extract and its applications. Molecules 2023, 28, 4629. [Google Scholar] [CrossRef]
- Kerketta, A.; Sahu, B. Chapter 13 Nanomaterials synthesis from medicinal plant extract. In Phytochemicals in Medicinal Plants; De Gruyter: Berlin, Germany, 2023; pp. 291–314. [Google Scholar] [CrossRef]
- Bagheri, A.R.; Aramesh, N.; Hasnain, M.S.; Nayak, A.K.; Varma, R.S. Greener fabrication of metal nanoparticles using plant materials: A review. Chem. Phys. Impact 2023, 7, 100255. [Google Scholar] [CrossRef]
- Kalaiselvi, A.; Roopan, S.M.; Madhumitha, G.; Ramalingam, C.; Elango, G. Synthesis and characterization of palladium nanoparticles using Catharanthus roseus leaf extract and its application in the photo-catalytic degradation. Spectrochim. Acta A Mol. Biomol. Spectrosc. 2015, 135, 116–119. [Google Scholar] [CrossRef] [PubMed]
- Roy, A.; Singh, V.; Sharma, S.; Ali, D.; Azad, A.K.; Kumar, G.; Bin Emran, T. Antibacterial and dye degradation activity of green synthesized iron nanoparticles. J. Nanomater. 2022, 2022, 3636481. [Google Scholar] [CrossRef]
- Fouad, A.; Hegazy, A.E.; Azab, E.; Khojah, E.; Kapiel, T. Boosting of antioxidants and alkaloids in Catharanthus roseus suspension cultures using silver nanoparticles with expression of CrMPK3 and STR Genes. Plants 2021, 10, 2202. [Google Scholar] [CrossRef]
- Xian, T.; Meng, Q.; Gao, F.; Hu, M.; Wang, X. Functionalization of luminescent lanthanide complexes for biomedical applications. Coord. Chem. Rev. 2023, 474, 214866. [Google Scholar] [CrossRef]
- Balaram, V. Rare earth elements: A review of applications, occurrence, exploration, analysis, recycling, and environmental impact. Geosci. Front. 2019, 10, 1285–1303. [Google Scholar] [CrossRef]
- Gimaev, R.; Komlev, A.; Davydov, A.; Kovalev, B.; Zverev, V. Magnetic and electronic properties of heavy lanthanides (Gd, Tb, Dy, Er, Ho, Tm). Crystals 2021, 11, 82. [Google Scholar] [CrossRef]
- Hou, W.; Wang, G.; Wu, X.; Sun, S.; Zhao, C.; Liu, W.-S.; Pan, F. Lanthanide clusters as highly efficient catalysts regarding carbon dioxide activation. New J. Chem. 2020, 44, 5019–5022. [Google Scholar] [CrossRef]
- Patil, A.S.; Patil, A.V.; Dighavkar, C.G.; Adole, V.A.; Tupe, U.J. Synthesis techniques and applications of rare earth metal oxides semiconductors: A review. Chem. Phys. Lett. 2022, 796, 139555. [Google Scholar] [CrossRef]
- Wiglusz, R.J.; Grzyb, T.; Lis, S.; Strek, W. Hydrothermal preparation and photoluminescent properties of MgAl2O4: Eu3+ spinel nanocrystals. J. Lumin. 2010, 130, 434–441. [Google Scholar] [CrossRef]
- Liang, X.; Kuang, S.; Li, Y. Solvothermal synthesis and luminescence of nearly monodisperse LnVO4 nanoparticles. J. Mater. Res. 2011, 26, 1168–1173. [Google Scholar] [CrossRef]
- Rudnev, A.V. Electrodeposition of lanthanides from ionic liquids and deep eutectic solvents. Russ. Chem. Rev. 2020, 89, 1463–1482. [Google Scholar] [CrossRef]
- Govindasamy, R.; Govindarasu, M.; Alharthi, S.S.; Mani, P.; Bernaurdshaw, N.; Gomathi, T.; Ansari, M.A.; Alomary, M.N.; Atwah, B.; Malik, M.S.; et al. Sustainable green synthesis of yttrium oxide (Y2O3) nanoparticles using Lantana camara leaf extracts: Physicochemical characterization, photocatalytic degradation, antibacterial, and anticancer potency. Nanomaterials 2022, 12, 2393. [Google Scholar] [CrossRef]
- Rashmi, B.N.; Harlapur, S.F.; Gurushantha, K.; Ravikumar, C.; Kumar, M.; Santosh, M.; Kumar, V.; Kumar, A.; Azad, A.K.; Murthy, H.A. Facile green synthesis of lanthanum oxide nanoparticles using Centella Asiatica and Tridax plants: Photocatalytic, electrochemical sensor and antimicrobial studies. Appl. Surf. Sci. Adv. 2022, 7, 100210. [Google Scholar] [CrossRef]
- Cotruvo, J.A. The chemistry of lanthanides in biology: Recent discoveries, emerging principles, and technological applications. ACS Cent. Sci. 2019, 5, 1496–1506. [Google Scholar] [CrossRef]
- Teo, R.D.; Termini, J.; Gray, H.B. Lanthanides: Applications in cancer diagnosis and therapy. J. Med. Chem. 2016, 59, 6012–6024. [Google Scholar] [CrossRef]
- Dong, H.; Du, S.-R.; Zheng, X.-Y.; Lyu, G.-M.; Sun, L.-D.; Li, L.-D.; Zhang, P.-Z.; Zhang, C.; Yan, C.-H. Lanthanide nanoparticles: From design toward bioimaging and therapy. Chem. Rev. 2015, 115, 10725–10815. [Google Scholar] [CrossRef]
- Sarkar, D.; Ganguli, S.; Samanta, T.; Mahalingam, V. Design of lanthanide-doped colloidal nanocrystals: Applications as phosphors, sensors, and photocatalysts. Langmuir 2019, 35, 6211–6230. [Google Scholar] [CrossRef]
- Zhang, L.; Long, S.; Jiao, H.; Liu, Z.; Zhang, P.; Lei, A.; Gong, W.; Pei, X. Cellulose derived Pd nano-catalyst for efficient catalysis. RSC Adv. 2022, 12, 18676–18684. [Google Scholar] [CrossRef] [PubMed]
- Nishu, S.K. Smart and innovative nanotechnology applications for water purification. Hybrid. Adv. 2023, 3, 100044. [Google Scholar] [CrossRef]
- Yadav, M.; Gupta, R.; Sharma, R.K. Green and sustainable pathways for wastewater purification. In Advances in Water Purification Techniques; Elsevier: Amsterdam, The Netherlands, 2019; pp. 355–383. [Google Scholar] [CrossRef]
- Vrchota, J.; Pech, M.; Rolínek, L.; Bednář, J. Sustainability outcomes of green processes in relation to industry 4.0 in manufacturing: Systematic review. Sustainability 2020, 12, 5968. [Google Scholar] [CrossRef]
- Jara, Y.S.; Mekiso, T.T.; Washe, A.P. Highly efficient catalytic degradation of organic dyes using iron nanoparticles synthesized with Vernonia Amygdalina leaf extract. Sci. Rep. 2024, 14, 6997. [Google Scholar] [CrossRef]
- Blanckenberg, A.; Malgas-Enus, R. Raspberry-like gold-decorated silica (SSx–AMPS–Au) nanoparticles for the reductive discoloration of dyes. SN Appl. Sci. 2019, 1, 787. [Google Scholar] [CrossRef]
- Agha, M.K.; Maatouk, B.; Mhanna, R.; El-Dakdouki, M.H. Catalytic degradation efficacy of silver nanoparticles fabricated using Actinidia deliciosa peel extract. J. Nanomater. 2024, 2024, 8813109. [Google Scholar] [CrossRef]
- Muthu, K.; Thangapushbam, V.; Rama, P.; Sivakami, S.; Jothika, M. Green synthesis, characterization and photocatalytic reduction of Congo red using silver nanoparticles from Millingtonia hortensis leaf extract. Res. Sq. 2023. [Google Scholar] [CrossRef]
- Ismail, M.; Khan, M.I.; Khan, M.A.; Akhtar, K.; Asiri, A.M.; Khan, S.B. Plant-supported silver nanoparticles: Efficient, economically viable and easily recoverable catalyst for the reduction of organic pollutants. Appl. Organomet. Chem. 2019, 33, e4971. [Google Scholar] [CrossRef]
- Srivastava, V.; Choubey, A.K. Synthesis of nanostructured silver particles using Citrus limetta peel extract for catalytic degradation of azo dyes through electron relay effect. Adv. Nat. Sci. Nanosci. Nanotechnol. 2019, 10, 45015. [Google Scholar] [CrossRef]
- Bhakya, S.; Muthukrishnan, S.; Sukumaran, M.; Muthukumar, M.; Kumar, S.T.; Rao, M.V. Catalytic degradation of organic dyes using synthesized silver nanoparticles: A green approach. J. Bioremediat. Biodegrad. 2015, 6, 1. [Google Scholar] [CrossRef]
- Rajasekar, R.; Thanasamy, R.; Samuel, M.; Edison, T.N.J.I.; Raman, N. Eco-friendly green synthesis of silver nanoparticles using Luffa acutangula: Synthesis, characterisation and catalytic degradation of methylene blue and malachite green dyes. Int. J. Environ. Anal. Chem. 2024, 104, 2255–2267. [Google Scholar] [CrossRef]
- Velidandi, A.; Sarvepalli, M.; Gandam, P.K.; Pabbathi, N.P.P.; Baadhe, R.R. Characterization, catalytic, and recyclability studies of nano-sized spherical palladium particles synthesized using aqueous poly-extract (turmeric, neem, and tulasi). Environ. Res. 2023, 228, 115821. [Google Scholar] [CrossRef]
- Anasdass, J.R.; Kannaiyan, P.; Gopinath, S.C.B. Biosynthesis of zerovalent iron nanoparticles for catalytic reduction of 4-nitrophenol and decoloration of textile dyes. Biotechnol. Appl. Biochem. 2022, 69, 2780–2793. [Google Scholar] [CrossRef] [PubMed]
- Kulkarni, S.; Jadhav, M.; Raikar, P.; Raikar, S.; Raikar, U. Core–shell novel composite metal nanoparticles for hydrogenation and dye degradation applications. Ind. Eng. Chem. Res. 2019, 58, 3630–3639. [Google Scholar] [CrossRef]
- Dobrucka, R. Biofabrication of Au–Pt nanoparticles using Asarum europaeum extract and evaluation of their activity in degradation of organic dyes. J. Inorg. Organomet. Polym. Mater. 2018, 28, 1953–1961. [Google Scholar] [CrossRef]
- Malik, M.A.; Alshehri, A.A.; Abomuti, M.A.; Danish, E.Y.; Patel, R. Bioengineered Matricaria recutita extract-assisted palladium nanoparticles for the Congo red dye degradation and catalytic reduction of 4-nitrophenol to 4-aminophenol. Toxics 2021, 9, 103. [Google Scholar] [CrossRef] [PubMed]
- Prabhu, M.S.A.; Sheela, G.E.; Mohammad, A.M.; Hegazy, R.A.; Florence, S.S.; Sarojini, V. Biogenic synthesis of silver, gold, and palladium nanoparticles using moringa oleifera seeds: Exploring photocatalytic, catalytic, and antimicrobial activities. Adv. Nat. Sci. Nanosci. Nanotechnol. 2024, 15, 15007. [Google Scholar] [CrossRef]
- Wang, X.; Hou, C.; Qiu, W.; Ke, Y.; Xu, Q.; Liu, X.Y.; Lin, Y. Protein-directed synthesis of bifunctional adsorbent-catalytic hemin-graphene nanosheets for highly efficient removal of dye pollutants via synergistic adsorption and degradation. ACS Appl. Mater. Interfaces 2017, 9, 684–692. [Google Scholar] [CrossRef]
- Zhang, W.; Zhou, T.; Qiu, J. Interfacial engineering of BiVO4 immobilized on sodium alginate aerogels enable synergistic photocatalytic-peroxymonosulfate degradation of rhodamine B. Polymers 2025, 17, 2204. [Google Scholar] [CrossRef]
- Quintero-Quiroz, C.; Botero, L.E.; Zárate-Triviño, D.; Acevedo-Yepes, N.; Saldarriaga Escobar, J.; Pérez, V.Z.; Javier Cruz Riano, L. Synthesis and characterization of a silver nanoparticle-containing polymer composite with antimicrobial abilities for application in prosthetic and orthotic devices. Biomater Res 2020, 24, 13. [Google Scholar] [CrossRef]
- Assis, M.; Robeldo, T.; Foggi, C.C.; Kubo, A.M.; Mínguez-Vega, G.; Condoncillo, E.; Beltran-Mir, H.; Torres-Mendieta, R.; Andrés, J.; Oliva, M.; et al. Ag nanoparticles/α-Ag2WO4 composite formed by electron beam and femtosecond irradiation as potent antifungal and antitumor agents. Sci. Rep. 2019, 9, 9927. [Google Scholar] [CrossRef]
- Lamoth, M.; Plodinec, M.; Scharfenberg, L.; Wrabetz, S.; Girgsdies, F.; Jones, T.E.; Rosowski, F.; Horn, R.; Schlögl, R.; Frei, E. Supported Ag nanoparticles and clusters for CO oxidation: Size effects and influence of the silver–oxygen interactions. ACS Appl. Nano Mater. 2019, 2, 2909–2920. [Google Scholar] [CrossRef]
- Kim, S.J.; Han, W.K.; Kang, S.G.; Han, M.S.; Cheong, Y.H. Formation of lanthanum hydroxide and oxide via precipitation. Solid. State Phenom. 2008, 135, 23–26. [Google Scholar] [CrossRef]
- Fabrichnaya, O.; Savinykh, G.; Schreiber, G.; Seifert, H.J. Experimental study of phase relations in the ZrO2–La2O3–Y2O3 system. Int. J. Mater. Res. 2009, 100, 1521–1528. [Google Scholar] [CrossRef]
- Singh, J.; Dutta, T.; Kim, K.-H.; Rawat, M.; Samddar, P.; Kumar, P. ‘Green’ synthesis of metals and their oxide nanoparticles: Applications for environmental remediation. J. Nanobiotechnol. 2018, 16, 84. [Google Scholar] [CrossRef] [PubMed]
- Yang, J.; Han, Y.; Luo, J.; Leifer, K.; Strømme, M.; Welch, K. Synthesis and characterization of amorphous magnesium carbonate nanoparticles. Mater. Chem. Phys. 2019, 224, 301–307. [Google Scholar] [CrossRef]
- Zhang, X.; Wang, Y.; Cheng, F.; Zheng, Z.; Du, Y. Ultrathin lanthanide oxides nanomaterials: Synthesis, properties and applications. Sci. Bull. 2016, 61, 1422–1434. [Google Scholar] [CrossRef]
- Vadivel, S.; Madkour, M.; Rajendran, S.; Sengottaiyan, C. Effective degradation of aqueous bisphenol-A using novel Ag2C2O4/Ag@GNS photocatalyst under visible light. Int. J. Hydrogen Energy 2023, 48, 6510–6520. [Google Scholar] [CrossRef]
- Maou, A.; Gouitaa, N.; Lamcharfi, T.D.; Kandri, N.I. Effect of calcination temperature on the stability of the perovskite materials—Study of structural and morphological properties. Ecol. Eng. Environ. Technol. 2023, 24, 1–8. [Google Scholar] [CrossRef]
- Ravi, G.; Sarasija, M.; Ayodhya, D.; Kumari, L.S.; Ashok, D. Facile synthesis, characterization and enhanced catalytic reduction of 4-nitrophenol using NaBH4 by undoped and Sm3+, Gd3+, Hf3+ doped La2O3 nanoparticles. Nano Converg. 2019, 6, 12. [Google Scholar] [CrossRef]
- Zhang, L.; Zhu, S.; Li, R.; Deng, W.; Hong, C.; Liu, D.; Guo, L. Ag-doped δ-MnO2 nanosheets as robust catalysts for toluene combustion. ACS Appl. Nano Mater. 2020, 3, 11869–11880. [Google Scholar] [CrossRef]
- Saad, S.K.M.; Umar, A.A.; Umar, M.I.A.; Tomitori, M.; Rahman, M.Y.A.; Salleh, M.M.; Oyama, M. Two-dimensional, hierarchical Ag-doped TiO2 nanocatalysts: Effect of the metal oxidation state on the photocatalytic properties. ACS Omega 2018, 3, 2579–2587. [Google Scholar] [CrossRef]
- Rahul, S.; George, A.; Jayakumar, G. Unraveling the photocatalytic performance of La2O3 nanoparticles for the degradation of six organic dyes. Langmuir 2025, 41, 16378–16390. [Google Scholar] [CrossRef]
- Ayub, A.; Ikram, M.; Haider, A.; Shahzadi, I.; Ul-Hamid, A.; Shahzadi, A.; Algaradah, M.M.; Fouda, A.M.; Nabgan, W.; Imran, M. Enhanced industrial dye degradation and antibacterial activity supported by the molecular docking study of yttrium and carbon sphere-doped lanthanum oxide nanostructures. ACS Omega 2023, 8, 37564–37572. [Google Scholar] [CrossRef]
- Rooshde, M.S.; Abdullah, W.R.W.; Ibrahim, N.F.; Ghazali, M.S.M.; Nik, W.M.N.W. Photocatalytic efficiency of lanthanide-doped zinc oxide for degradation of methylene blue dye. J. Sustain. Sci. Manag. 2018, 13, 153–162. [Google Scholar]
- Wazir, W.; Ahmad, Z.; Zulfiqar, S.; Cochran, E.W.; Mubarik, S.; Kousar, T.; Somaily, H.; Shim, J.-J.; Alsalmah, H.A.; Aadil, M. Synergistic effects of noble metal doping and nanoengineering on boosting the azo dye mineralization activity of nickel oxide. Ceram. Int. 2023, 49, 38026–38035. [Google Scholar] [CrossRef]
- Ershov, V.A.; Ershov, B.G. Oxidative dissolution and the aggregation of silver nanoparticles in drinking and natural waters: The influence of the medium on the process development. Toxics 2024, 12, 757. [Google Scholar] [CrossRef] [PubMed]
- Jin, Q.; Ma, L.; Zhou, W.; Shen, Y.; Fernandez-Delgado, O.; Li, X. Smart paper transformer: New insight for enhanced catalytic efficiency and reusability of noble metal nanocatalysts. Chem. Sci. 2020, 11, 2915–2925. [Google Scholar] [CrossRef]
- Dhiman, P.; Rana, G.; Kumar, A.; Dawi, E.A.; Sharma, G. Rare earth doped ZnO nanoparticles as spintronics and photo catalyst for degradation of pollutants. Molecules 2023, 28, 2838. [Google Scholar] [CrossRef]
- Isacfranklin, M.; Ameen, F.; Ravi, G.; Yuvakkumar, R.; Hong, S.; Velauthapillai, D.; AlKahtani, M.D.; Thambidurai, M.; Dang, C. Y2O3 nanorods for cytotoxicity evaluation. Ceram. Int. 2020, 46, 20553–20557. [Google Scholar] [CrossRef]
- Singh, B. Lanthanide-based catalysts for electrochemical water splitting: Unraveling the interplay of structure, properties, and performance. Chem. Commun. 2025, 61, 9753–9779. [Google Scholar] [CrossRef] [PubMed]
- Prabhavathy, S.; Arivuoli, D. Visible light-induced Silver and Lanthanum co-doped BiVO4 nanoparticles for photocatalytic dye degradation of organic pollutants. Inorg. Chem. Commun. 2022, 141, 109483. [Google Scholar] [CrossRef]
- Zhang, C.-L.; Qiu, X.-Y.; Liu, S.-J. Synthesis, crystal structure and antimicrobial activity of a linear trinuclear nickel(II) complex with schiff base ligand. Acta Chim. Slov. 2019, 66, 484–489. [Google Scholar] [CrossRef]
- Weber, J.T. (Ed.) Antimicrobial Resistance; Karger: Basel, Switzerland, 2010; Volume 6. [Google Scholar] [CrossRef]
- Ansel, H.C.; Norred, W.P.; Roth, I.L. Antimicrobial activity of dimethyl sulfoxide against Escherichia coli, Pseudomonas aeruginosa, and Bacillus megaterium. J. Pharm. Sci. 1969, 58, 836–839. [Google Scholar] [CrossRef] [PubMed]
- Kirkwood, Z.; Millar, B.; Downey, D.; Moore, J. Antimicrobial effect of dimethyl sulfoxide and N, N-dimethylformamide on Mycobacterium abscessus: Implications for antimicrobial susceptibility testing. Int. J. Mycobacteriol. 2018, 7, 134. [Google Scholar] [CrossRef] [PubMed]

| Control | (La/Y/Ag) | (Y/Ag) | (La/Ag) | Microorganism |
|---|---|---|---|---|
| 39 ± 1 | 19 ± 0.5 | 18 ± 0.5 | 20 ± 0.5 | A. niger |
| 30 ± 0.2 | 21 ± 0.5 | 20 ± 0.5 | 21 ± 0.5 | Candida albicans (ATCC 10221) |
| 22 ± 0.2 | 19 ± 0.5 | 17 ± 0.5 | 18 ± 0.5 | E. coli (ATCC 8739) |
| 27 ± 0.1 | 20 ± 0.5 | 18 ± 0.5 | 19 ± 0.5 | Salmonella typhi (ATCC 6539) |
| 27 ± 1 | 21 ± 0.5 | 19 ± 0.5 | 20 ± 0.5 | Staph. aureus (ATCC 6538) |
| 27 ± 1 | 20 ± 0.5 | 18 ± 0.5 | 19 ± 0.5 | Bacillus subtilis (ATCC 6633) |
Disclaimer/Publisher’s Note: The statements, opinions and data contained in all publications are solely those of the individual author(s) and contributor(s) and not of MDPI and/or the editor(s). MDPI and/or the editor(s) disclaim responsibility for any injury to people or property resulting from any ideas, methods, instructions or products referred to in the content. |
© 2025 by the authors. Licensee MDPI, Basel, Switzerland. This article is an open access article distributed under the terms and conditions of the Creative Commons Attribution (CC BY) license (https://creativecommons.org/licenses/by/4.0/).
Share and Cite
Alsawqaee, S.M.; Alzahrani, E.A.; Bakhsh, E.M.; Akhtar, K.; Khan, S.B. Synthesis of Plant-Mediated Silver-Doped Metal Oxides Using Catharanthus roseus and Evaluation of Their Catalytic and Biological Activities. Catalysts 2025, 15, 1001. https://doi.org/10.3390/catal15101001
Alsawqaee SM, Alzahrani EA, Bakhsh EM, Akhtar K, Khan SB. Synthesis of Plant-Mediated Silver-Doped Metal Oxides Using Catharanthus roseus and Evaluation of Their Catalytic and Biological Activities. Catalysts. 2025; 15(10):1001. https://doi.org/10.3390/catal15101001
Chicago/Turabian StyleAlsawqaee, Samira M., Eman A. Alzahrani, Esraa M. Bakhsh, Kalsoom Akhtar, and Sher Bahadar Khan. 2025. "Synthesis of Plant-Mediated Silver-Doped Metal Oxides Using Catharanthus roseus and Evaluation of Their Catalytic and Biological Activities" Catalysts 15, no. 10: 1001. https://doi.org/10.3390/catal15101001
APA StyleAlsawqaee, S. M., Alzahrani, E. A., Bakhsh, E. M., Akhtar, K., & Khan, S. B. (2025). Synthesis of Plant-Mediated Silver-Doped Metal Oxides Using Catharanthus roseus and Evaluation of Their Catalytic and Biological Activities. Catalysts, 15(10), 1001. https://doi.org/10.3390/catal15101001

